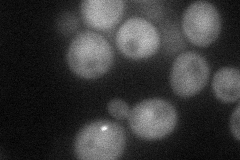

View description
Processivity factor required for the ubiquitination activity of the anaphase promoting complex (APC), mediates the activity of the APC by contributing to substrate recognition; involved in cyclin proteolysis
Localization:
Intensity:
Fold change:
Significance:
-
C’ GFP library in SD

below threshold16.33 -
N' NOP1pr-GFP in SD
cytosol52.0611 -
N' TEF2pr-mCherry in SD

missing0 -
N' NATIVEpr-GFP in SD

missing0 -
N' TEF2pr-VC and Cyto-VN in SD

#N/A0 -
C’ GFP library in SD+DTT

cytosol18.171.11No -
C’ GFP library in SD+H2O2

cytosol16.521.01No -
C’ GFP library in Starvation Media

cytosol14.390.88No -
C’ GFP library on the background of Pup2-DaMP

below threshold -
C’ GFP library on the background of CCT mutant

below threshold17.18771.05197No
